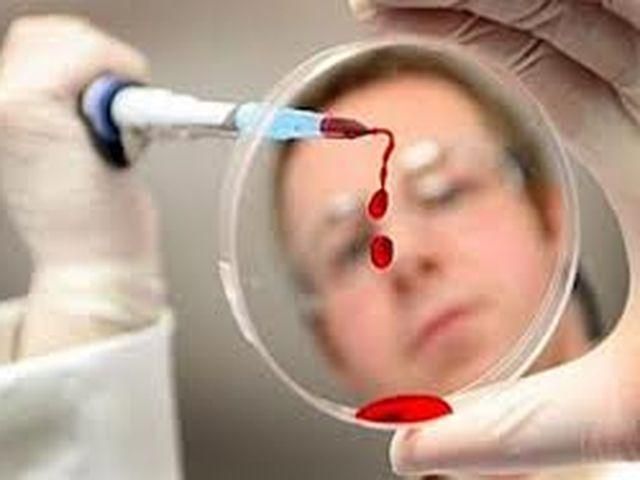
Два китайца умерли от свиного гриппа Два китайца умерли от свиного гриппа

Эти два смертельных случая стали первыми с 2010 года.
По данным китайских СМИ, число заболеваний гриппом в китайской столице достигло наивысшей отметки, а штамм H1N1 стал доминирующим.
Как известно, вспышку этого вируса зарегистрировали в Мексике в 2009 году. Именно оттуда он начал быстро распространяться по миру.
К слову, в Киеве один человек заболел свиным гриппом.